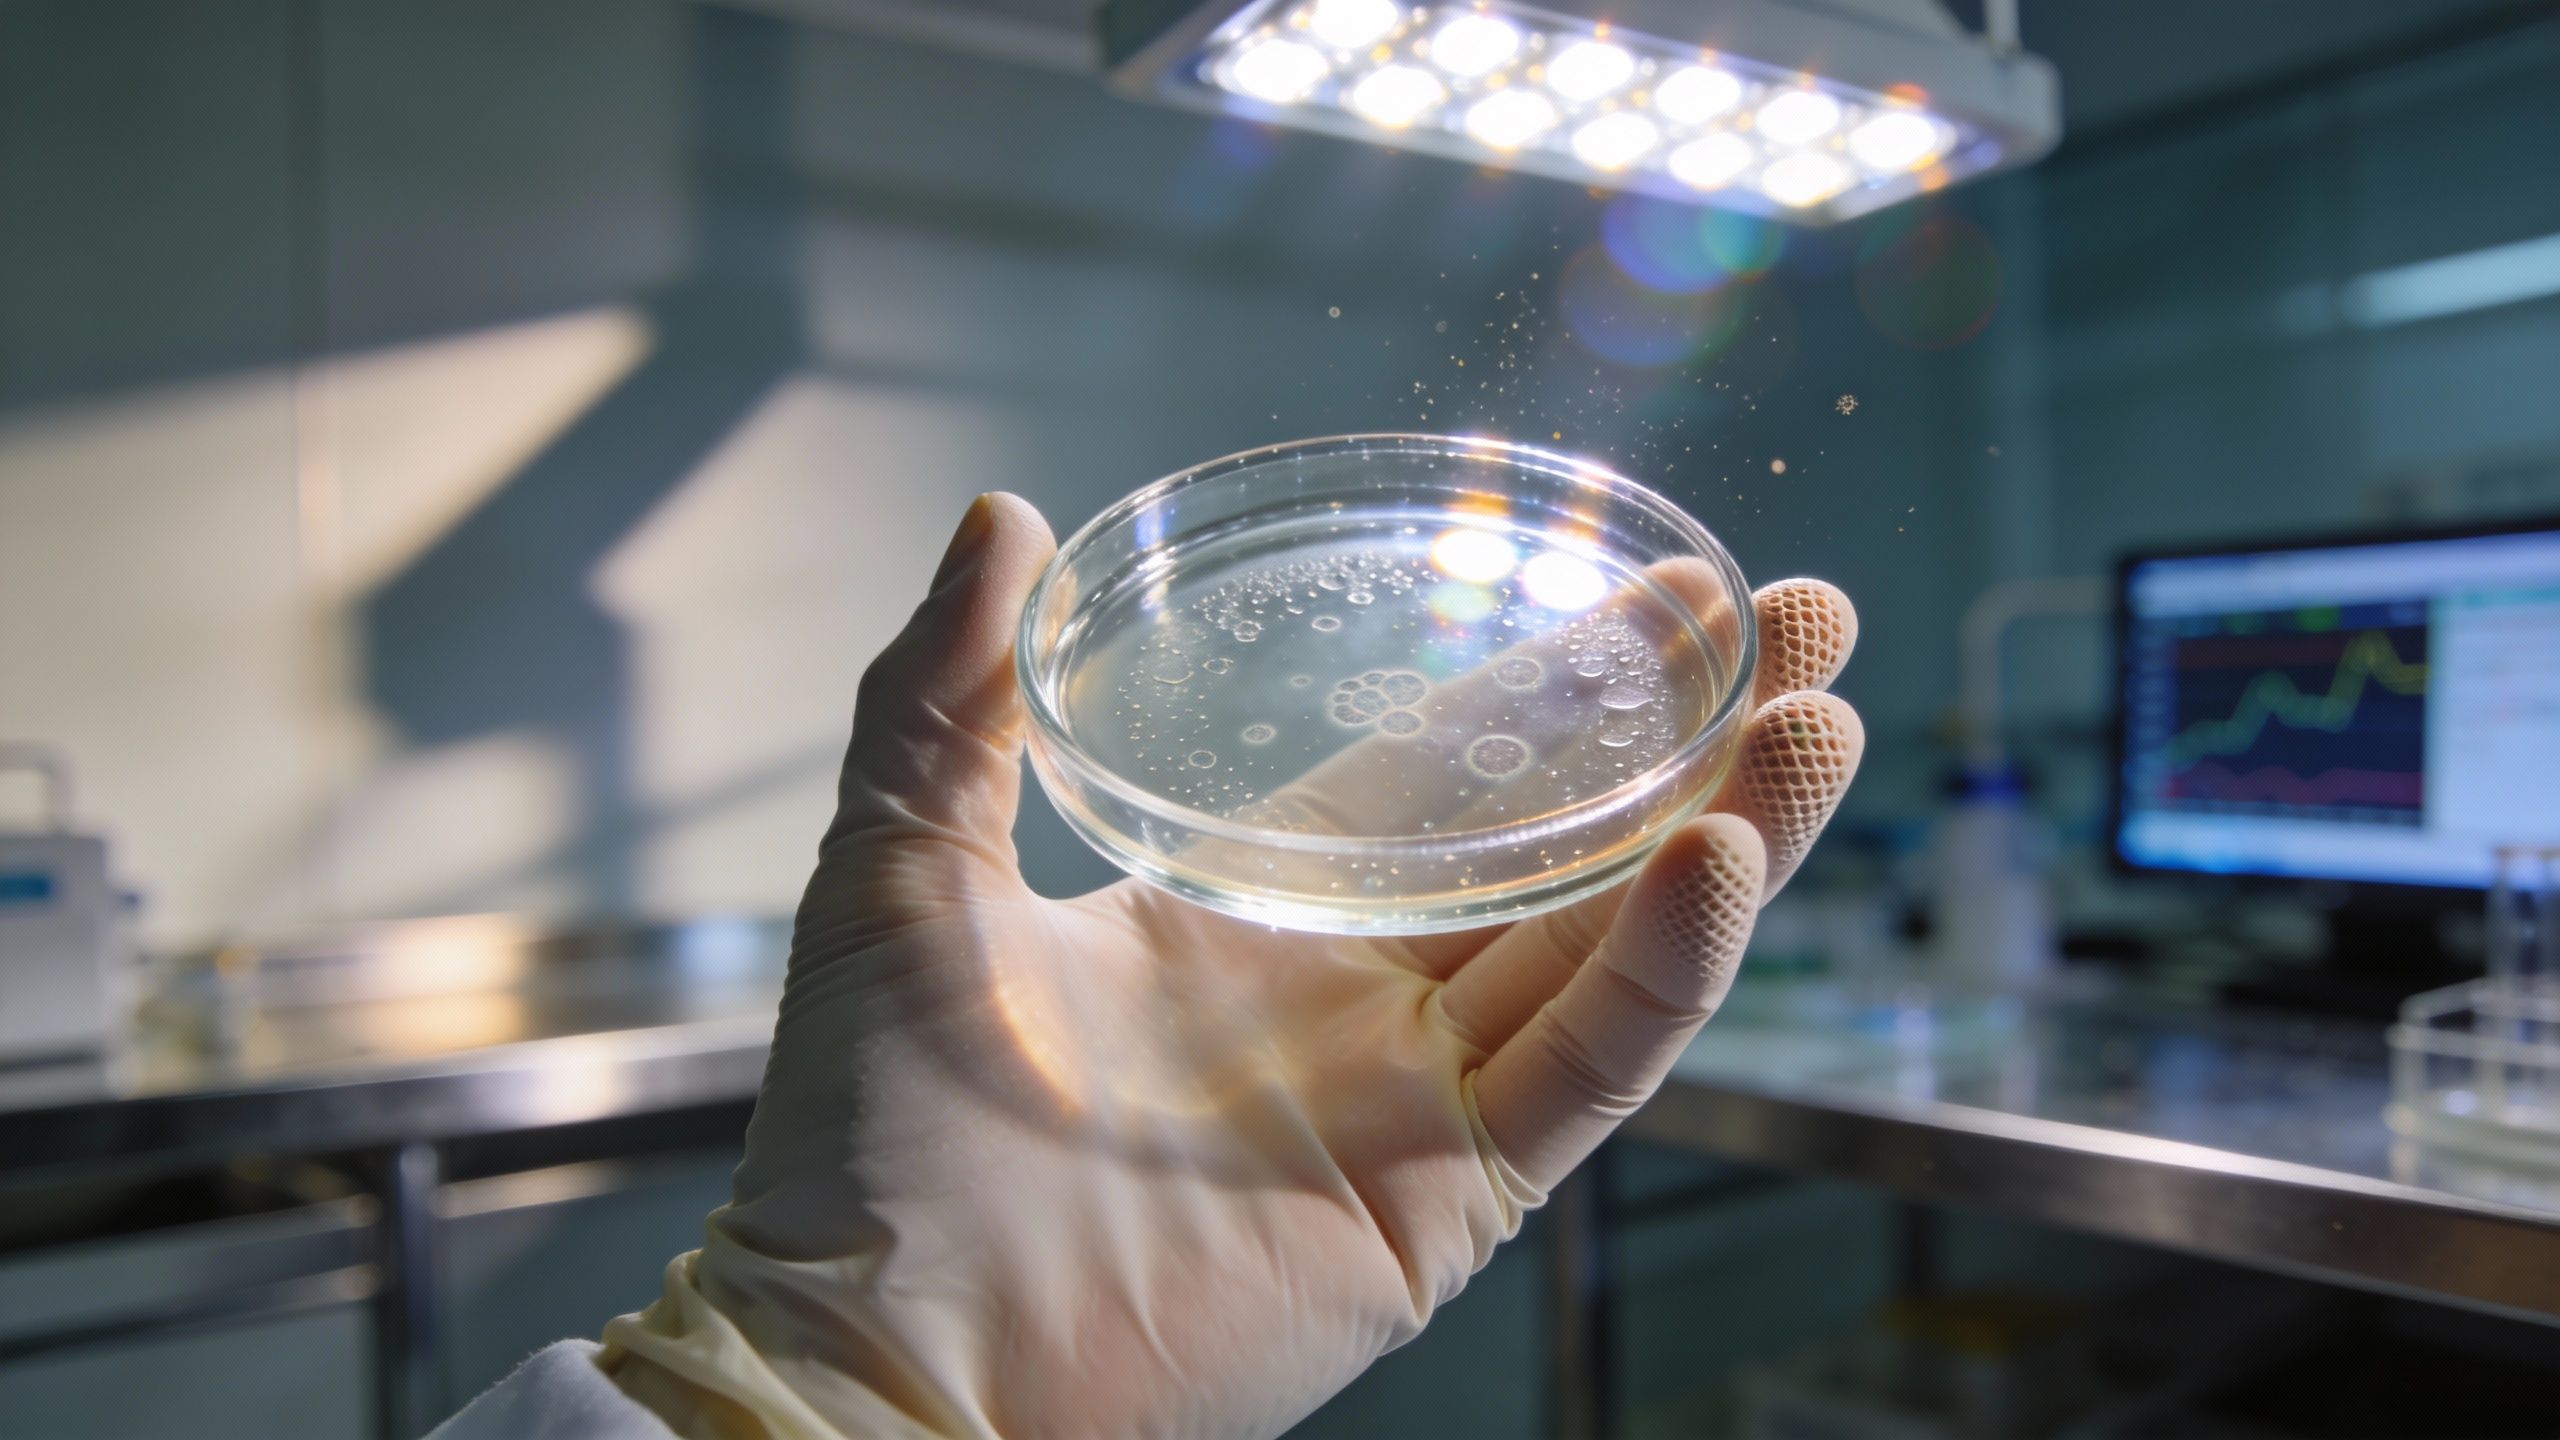

Ce « contrôleur aérien » caché dans vos cellules que les virus savent pirater
Auteur: Mathieu Gagnon
Une faille insoupçonnée dans notre défense

On imagine souvent notre système immunitaire comme une armée infaillible, parfaitement disciplinée. Pourtant, même les meilleures défenses ont leurs faiblesses, et parfois, l’ennemi est plus malin que nous le pensions. C’est exactement ce que vient de mettre en lumière une collaboration fascinante entre des chercheurs de l’Université Monash et du Lions Eye Institute.
Leur découverte ? Ils ont identifié une protéine tissulaire spécifique qui agit comme un véritable contrôleur de trafic central pour nos cellules immunitaires. Le problème, c’est que ce chef d’orchestre vital peut être littéralement pris en otage. Publiée dans la prestigieuse revue Nature, cette étude dévoile un mécanisme clé qui contrôle la coordination des réponses immunitaires, et surtout, comment un virus très courant parvient à saboter tout le système de l’intérieur. C’est un peu effrayant, mais c’est surtout une avancée majeure pour la science.
CD44 : La cible privilégiée du sabotage viral
Alors, comment ça marche exactement ? Les recherches révèlent l’existence d’une molécule, baptisée CD44. C’est elle qui contrôle, de manière centralisée, tout le réseau de cellules de soutien qui guident le fonctionnement de notre système immunitaire. Imaginez un instant ce réseau : à l’intérieur, on trouve ce qu’on appelle des cellules stromales. Ce sont elles qui aident les cellules immunitaires à se déplacer efficacement et, point crucial, à échanger les informations nécessaires pour combattre les infections, répondre aux vaccins ou simplement nous garder en bonne santé.
Mais voilà le hic. L’équipe de recherche a découvert que le cytomégalovirus (ou CMV pour les intimes) a trouvé le moyen de détourner ce système. Comment ? En produisant sa propre protéine qui va bloquer le fonctionnement de CD44 sur les cellules stromales. Résultat : le trafic des cellules immunitaires déraille à la source, et la réponse antivirale du corps s’en trouve affaiblie. C’est d’une efficacité redoutable.
La Professeure Mariapia Degli-Esposti, qui a dirigé ces recherches, ne cache pas l’importance de cette trouvaille. Elle porte d’ailleurs une double casquette impressionnante : elle est responsable de l’immunologie expérimentale et virale au Monash Biomedicine Discovery Institute, et responsable de l’immunologie expérimentale au Lions Eye Institute. Selon elle, ces résultats changent fondamentalement notre compréhension des signaux qui façonnent la fonction immunitaire.
Elle utilise d’ailleurs une image très parlante : « Pensez au système immunitaire comme à une ville animée avec des millions de cellules patrouillant pour nous garder en sécurité », explique-t-elle. « CD44 agit comme le contrôleur de trafic central ; il maintient les cellules immunitaires en mouvement et coordonne leurs interactions au bon endroit et au bon moment. » Notre étude, poursuit-elle, identifie CD44 comme un régulateur maître. Elle montre que les virus peuvent saper l’immunité non seulement en attaquant directement les cellules immunitaires, mais aussi en ciblant l’infrastructure tissulaire essentielle sur laquelle elles comptent. C’est, pour le dire simplement, une façon totalement nouvelle pour un virus de cibler une réponse immunitaire.
Apprendre de l’ennemi pour mieux soigner
Ce qui est fascinant avec la science, c’est qu’une mauvaise nouvelle — comme la capacité d’un virus à nous pirater — peut déboucher sur des espoirs thérapeutiques inattendus. Le Dr Chris Andoniou, co-responsable de l’étude et chercheur principal au Monash Biomedicine Discovery Institute ainsi qu’au Lions Eye Institute, souligne que ces découvertes ont des implications vastes pour la santé humaine.
Le raisonnement est le suivant : puisque CD44 joue un rôle si central dans la régulation de l’activité immunitaire, pourquoi ne pas s’inspirer du virus ? « Des médicaments inspirés par la protéine virale identifiée dans cette étude pourraient être développés pour atténuer précisément l’inflammation nocive », avance le Dr Andoniou. C’est un changement de paradigme intéressant.
En apprenant du virus, nous pourrions être capables de concevoir des molécules thérapeutiques qui réduisent en toute sécurité une activation immunitaire excessive. Cela pourrait, à terme, aider à gérer et traiter des maladies auto-immunes, où le corps s’attaque lui-même. « Nous en sommes encore aux premiers stades, mais c’est un développement passionnant », tempère-t-il avec prudence, tout en laissant transparaître un réel optimisme.
Conclusion : Une nouvelle carte routière pour l’immunologie

En fin de compte, cette découverte nous rappelle à quel point notre biologie est complexe et interconnectée. Ce n’est pas seulement une histoire de cellules qui se battent, mais aussi une question de logistique, de « trafic » et d’infrastructures. En comprenant comment le cytomégalovirus s’attaque à nos routes intérieures plutôt qu’à nos soldats, les chercheurs de Monash et du Lions Eye Institute ouvrent la voie à des traitements plus fins, plus intelligents.
L’avenir nous dira si cette stratégie inspirée par un virus permettra de soulager les patients souffrant d’inflammations chroniques, mais une chose est sûre : nous ne regarderons plus jamais notre système immunitaire de la même façon.
Selon la source : medicalxpress.com
Créé par des humains, assisté par IA.